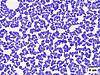
今までなかった肌の悪玉菌へアプローチ(肌荒れケアの新常識)、 「DR.Phageスキンケアローション」一般発売開始!

[研究・リサーチ]の専門家・プロ …7人
東京都の研究・リサーチの専門家・コンサルタント
日本各地に事務所を構える「研究・リサーチ」に関する専門家の中から、あなたにぴったりのプロをお探しいただけます。 専門家の気になるプロフィールや取材記事、経歴、サービス内容を掲載しています。
現在の検索条件
東京都×研究・リサーチ
+フリーワードで絞込み
1~7人を表示 / 全7件
[東京都/研究・リサーチ]
建築工事費の適正化を図り、コストマネジメントの新分野を切り開く存在に
建築構造物の事業計画から工程、使用に係る維持・管理まで、全ての工程で重要とされるコストマネジメント。 高田馬場に事務所を置く「建築査定コンサルティング」は、建築会社や設計事務所とは異なる独立した...取材記事の続きを見る≫
- 職種
- 建築工事費査定コンサルタント
- 専門分野
- 会社名
- 株式会社建築査定コンサルティング
- 所在地
- 東京都新宿区高田馬場1-28-7 高田馬場ヒルサイドパレス508
[東京都/研究・リサーチ]
「経済を自分ごとに」:行動データでひも解く、新しい人材育成のかたち
金融経済教育の分野でグローバルに事業を展開する「ベータインテグラル」では、EdTech x HRTechの領域で以下のサービスを提供しています。・Beta Investors NISA:企業向け金融経済教育プログラム(NISA版)...取材記事の続きを見る≫
- 職種
- 社会イノベーター
- 専門分野
- 会社名
- ベータインテグラル株式会社
- 所在地
- 東京都品川区北品川5-5-15-4F
[東京都/研究・リサーチ]
主にビジネスの場において、独自開発したシステムの利用でコミュニケーションミスを防ぐ
今日、在宅ワークが増えていますが、それに伴いビジネスの場でさまざまなトラブルも起きているようです。オンライン会議やチャットツールでの会話、電子メールでのやり取りで発生するコミュニケーションのミス...取材記事の続きを見る≫
- 職種
- 弁理士
- 専門分野
- 事務所名
- 濱田国際特許商標事務所/通心工学株式会社
- 所在地
- 東京都調布市深大寺北町6丁目
[東京都/研究・リサーチ]
不正アクセスなどの情報を収集・分析し、日本のサイバーセキュリティ対策を構築
企業のDX(デジタルトランスフォーメーション)が進む中で、自社のIT資産や顧客情報を守るための施策は、より一層重要性を増しています。 「日本企業の備えは海外製品に大きく依存しており、脅威に対するデ...取材記事の続きを見る≫
- 職種
- プログラマー
- 専門分野
- 会社名
- RainForest
- 所在地
- 東京都杉並区成田西 2-8-10
[東京都/研究・リサーチ]
人間工学の視点から商品開発をアドバイスし、人に優しいワークスタイルを提案
「競争が激しい現代において、競合他社と差別化を図れる商品をリリースして業績を上げたい、自社のブランド力を高めたいという事業者さまのお力になります」と語るのは、東京都を拠点にアドバイザーとして活動...取材記事の続きを見る≫
- 職種
- 商品企画・人間工学アドバイザー
- 専門分野
- 所在地
- 東京都練馬区関町南2
[東京都/研究・リサーチ]
安全なモノづくりのお手伝いをする、最良のパートナーを目指す
「製品は一連のものづくりプロセスを経て市場に出ます。私どもは、製品を市場に送り出す最終段階を担います」と話すのは、「ナノテックシュピンドラー」代表取締役社長のシュピンドラー千恵子さん。厚生労働省...取材記事の続きを見る≫
- 職種
- 指定管理医療機器の認証機関、製品安全試験等
- 専門分野
- 会社名
- ナノテックシュピンドラー株式会社
- 所在地
- 千葉県柏市柏インター南4-6
[東京都/研究・リサーチ]
性感染症予防の研究とデリケートゾーン専門外来の臨床から、予防医療の進化に貢献
関東を中心に、全国に八つのクリニックを展開する「医療法人社団予防会」では、性感染症の検査をシステム化。利用者の負担が少ない効率的な検査と治療体制を組んでいます。 新宿駅東口から徒歩約5分と、ア...取材記事の続きを見る≫
- 職種
- 医師
- 専門分野
- 医院名
- 医療法人社団予防会新宿サテライトクリニック
- 所在地
- 東京都新宿区新宿三丁目22-11 RSビル7F
この分野の専門家が書いたコラム
今までなかった肌の悪玉菌へアプローチ(肌荒れケアの新常識)、 「DR.Phageスキンケアローション」一般発売開始!
2025-11-08
私は新宿サテライトクリニック院長を務めながら、菌へ直接アプローチするバクテリオファージの研究を進め、社会実装を目指し、株式会社DR.Phageを起業しました。 株式会社DR.Phageから、バクテリオファージを使っ...

DR.Phageスキンケアローションのクラウドファンディング開始中!
2025-09-28
私が代表を務める株式会社DR.Phage、院長を務めるクリニックの母体の予防会と早稲田大学が時間をかけて準備してきた、肌荒れ防止・美肌効果を持つ化粧水 <DR.Phageスキンケアローション> のクラウドファンデ...

【専門医解説】デリケートゾーンの症状の原因は、、、実はほとんど性病ではありません!
2025-02-07
女性は デリケートゾーンに、かゆみやおりものの増加などで悩まれる ことが多いのではないでしょうか? その度に、性病ではないか?と思われる方もいると思います。 デリケートゾーンの症状は性病を疑え!という世間的な...





